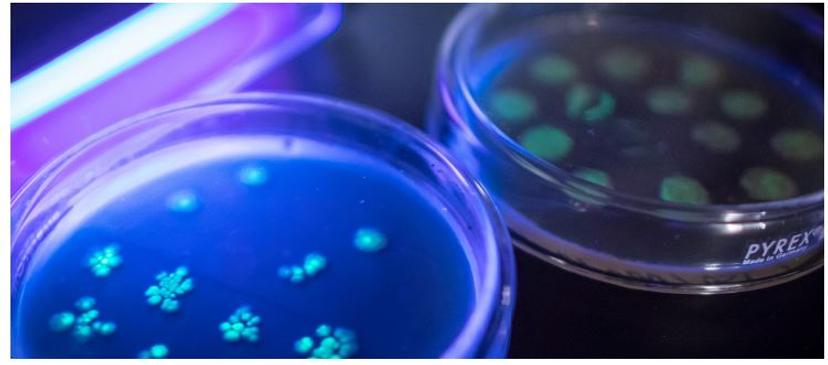

How Gut Microbes Control our Health: Latest News, Methods and Interviews
Read the latest on how 39 trillion bacteria in the gut regulate our health
1 Jul 2018
You can address yourself in plural because you are never alone – 39 trillion bacteria live inside your gut and control your health. These gut microbes, we now know, have a direct influence on our immune system, emotions, and even cognition.
Much of the current efforts by scientists are dedicated towards characterizing the repertoire of these microbes (who are they and what do they do), designing experiments to tease out their role (how do germ-free animals behave; what if fecal transplants can change our response to drugs) and developing new technologies to accelerate the microbiome research (digital PCR, shotgun metagenomics, miniaturization and multiplexing).
In this special feature, Anita Ramanathan, associate editor for life sciences at SelectScience, has curated useful resources that can keep you updated on this topic.

How can I improve my experiments?

1. Detect, Identify, and Quantify Microbial Targets with Droplet Digital PCR
Digital PCR offers advantages in microbial identification and quantification, detection of rare targets and pathogens, and assessment of viral loads, enabling the study of complex systems of microbial communities in various environments. This poster by Bio-Rad demonstrates the use of Digital PCR for studying physical linkage between physiological genes of interest, pathogen detection and viral load quantification.

2. Shotgun Metagenomics
Dr. Rob Knight, Professor of Pediatrics and Computer Science & Engineering at the University of California, San Diego, explains how to use shotgun metagenomics to reveal the impact of the gut microbiome.
3. Extraction of Live Bacteria and Recombinant DNA
Soil microbiome studies aim to characterize the microbial repertoire. This poster by OMNI International evaluates the recovery and detection of a modified bacterium from spiked soil samples by optimizing bead-milling methods.

4. Profiling Gut Microbiotica using Luminex xMAP Technology
Learn about a standardized DNA probe-based assay for profiling the gut microbiota. Combining Luminex xMAP® technology with the MagPlex® Microspheres is well suited for the final steps of sorting and detection.
What are the experts saying?

1. The Burglary Microbiome Project
No crime should ever rely on a singular piece of evidence. Microbial fingerprinting can serve as a forensic scientist’s tool, strengthening and supplementing investigative material.

2. The ‘Gut Feeling’ is Real: Gut Bacteria Influence Stress and Anxiety
Research from Dr. Gerard Clarke’s lab reveals how gut microbes can affect emotions. A special type of psychobiotic, when given to human volunteers, reduced human stress and anxiety. In this video, Clarke explains translating these findings into the lab using animal models.
Watch Video
What's in the news?

1. Gut Microbes Drive Fat Build-Up Around the Waist
Genes can no longer take all the blame for our waistline. In the largest twin study concerning the gut-health relationship, scientists at King’s College London analyzed the fecal metabolome of 500 pairs of twins. Their goal: to find out how the gut is involved in fat distribution around the waistline.
An analysis of fecal metabolites found that less than a fifth of gut processes could be attributed to hereditary factors, but 67.7% of gut activity was found to be influenced by environmental factors, mainly a person’s regular diet.
2. Exploring the Gut-Brain Connection for Insights into Multiple Sclerosis
Food can control inflammation pathways in the brain. A study performed by researchers at Brigham and Women’s Hospital (BWH) found evidence that changes in diet and gut flora may influence astrocytes in the brain, and, consequently, neurodegeneration. A genome-wide transcriptional analysis on astrocytes in a mouse model of MS identified a molecular pathway involved in inflammation.
3. Can a Test Reveal Gut Microbial Composition?
People with irritable bowel syndrome (IBS) are recommended a special diet that is low in fermentable oligosaccharides, disaccharides, monosaccharides, and polyols (FODMAPs). This diet is demanding but not all patients respond to it. There is, therefore, a need for a preselection test. A test developed by Genetic Analysis (GA) gives a rapid and accurate picture of the gut microbiota. This test, called the GA-map Dysbiosis Test, was able to distinguish the responders to the FODMAP diet from the non-responders, thereby providing a tool to manage IBS symptoms.

4. Good Bacteria Control Your Genes
Not all bacteria are bad. New research shows that good bacteria control gene activity. Led by Dr. Patrick Varga-Weisz, the study shows how chemicals produced by bacteria in the gut from the digestion of fruit and vegetables can affect genes in the cells of the gut lining. These molecules, called short-chain fatty acids, can move from the bacteria and into our own cells where they can trigger processes that change gene activity, ultimately affecting how our cells behave.
Watch this space for yet another exclusive microbiome article. Plus, help your peers by leaving a 2-minute expert review here.